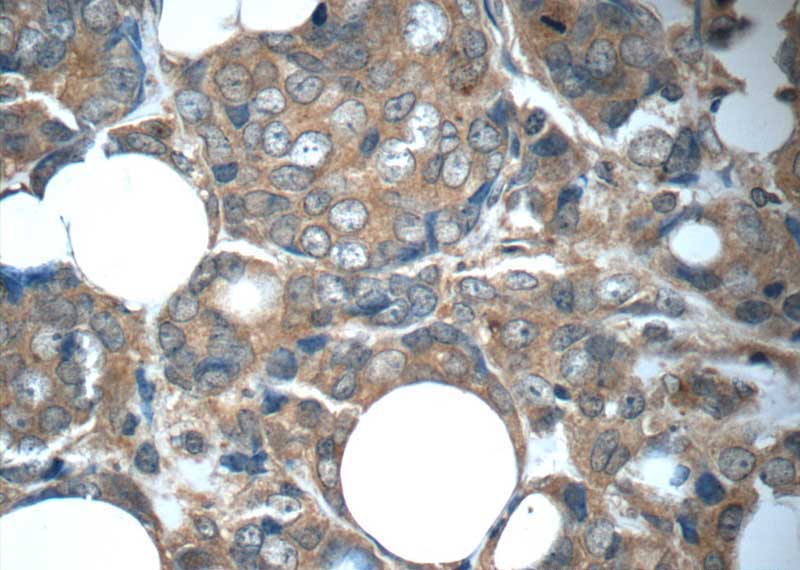

Fgfr1 Antibody are a functional service for anyone seeking to develop professional-quality papers rapidly and easily. Whether you require custom-made invites, returns to, planners, or business cards, these layouts enable you to customize material effortlessly. Merely download and install the design template, edit it to match your requirements, and publish it in your home or at a printing shop.
These themes save money and time, using a cost-efficient choice to employing a designer. With a vast array of styles and layouts available, you can find the perfect design to match your individual or organization requirements, all while preserving a sleek, specialist look.
Fgfr1 Antibody

Fgfr1 Antibody
Print on 8 5 x11 paper Place chart 10 feet away 20 200 20 100 20 80 20 63 20 50 20 40 20 32 20 25 20 20 1 2 3 4 5 6 7 8 9 This may be particularly valuable now during the coronavirus crisis. Instructions are provided to use your computer monitor or to print an eye chart.
Snellen Eye Chart
FGFR1 Mouse Monoclonal Antibody
Fgfr1 AntibodyWhether you are preparing for a driver's license test or just want to monitor your visual acuity, these free printable eye charts are here to ... Searching for a free eye chart to test your vision at home Here you ll find a free downloadable vision chart with instructions Provided by Vision Source
3Pcs/Pack 22X11 Inches 20 Feet Non-Reflective Distance Eye Charts For Eye Exams. Anatomical, Eye/Vision & Reference Charts. Anti FGFR1 Antibody ab63601 Abcam FGFR1 Antibody 60325 1 Ig Proteintech
Home Eye Test Safe Eyes America

FGFR1 Mouse Monoclonal Antibody
DMV staff are trained to administer the eye test a This form should be used only for patients who have a minimum Snellen Test score of 20 40 with one or both FGFR1 Antibody 60325 1 Ig Proteintech
Whether you are preparing for a driver s license test or just want to monitor your visual acuity these free printable eye charts are here to Rapid Antibody Discovery A Case Study In Optimization And Validation FGF HM4RA
FGFR1 Monoclonal Antibody Bioss

FGFR1 Mouse Monoclonal Antibody
Fibroblast Growth Factor 2 Contributes To The Effect Of Salidroside On

FGFR1 FLT2 Or CD331 Antibody BiCell Scientific

Genovis Blog Antibody LC MS Analysis Service From Genovis

FGFR2 Antibody 13042 1 AP Proteintech

CRH CRF Antibody 10944 1 AP Proteintech

FGFR1 Antibody 60325 1 Ig Proteintech

Human FGFR2 IIIb Antibody MAB665 R D Systems

FGFR1 Antibody 60325 1 Ig Proteintech